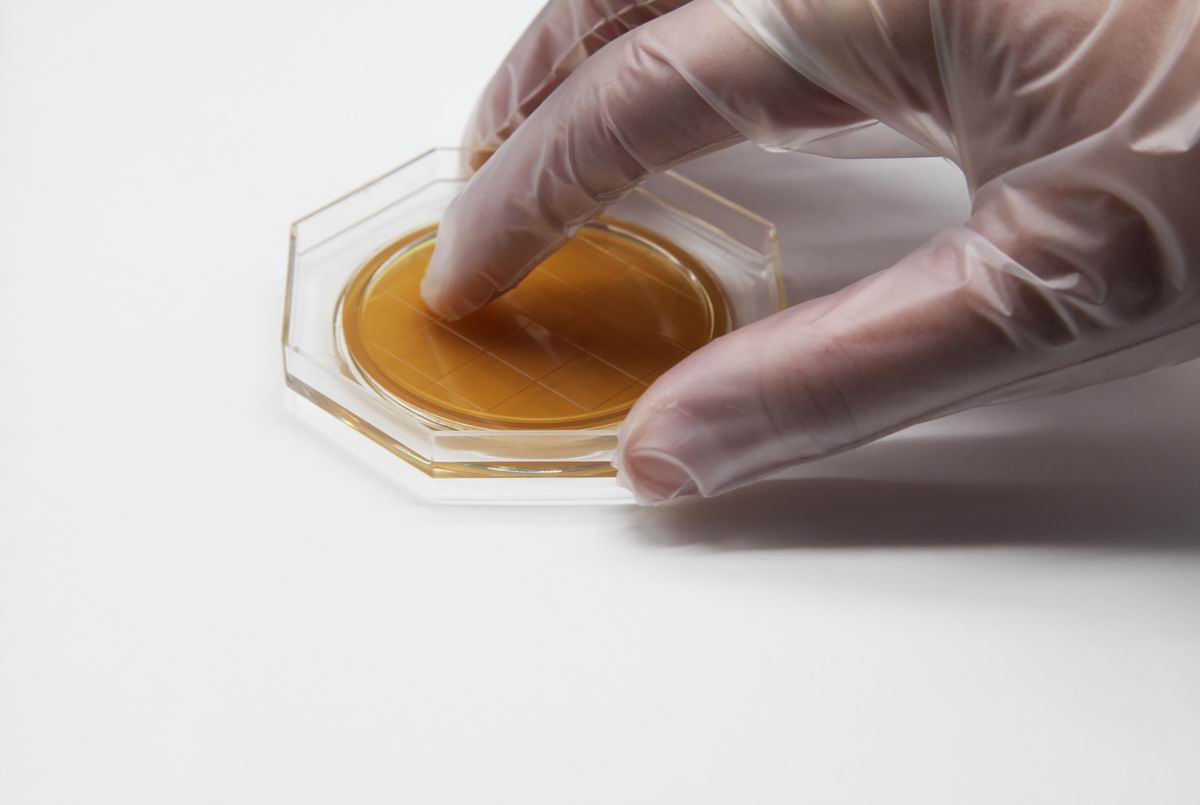

安科生物制品(上海)有限公司成立于2004年4月,由日本ELMEX株式会社投资。公司主要致力于微生物实验使用的快速检测产品的研究、开发、生产和销售。产品涉及食品、化妆品、饮料、医疗健康、第三方检测等相关行业的微生物检测。公司已通过IS09001:2015。
自成立以来,公司以“提供专业的微生物检测整体解决方案”为主题,产品涵盖了微生物样品采集至结果分析的全过程,包括各检验阶段所需的耗材、试剂盒和小型设备。拥有中日多项专利技术。公司产品大部分销往日本,东南亚及欧美等地区。通过了日本食品行业品质管理的严格考核,受到行业人员的青睐。